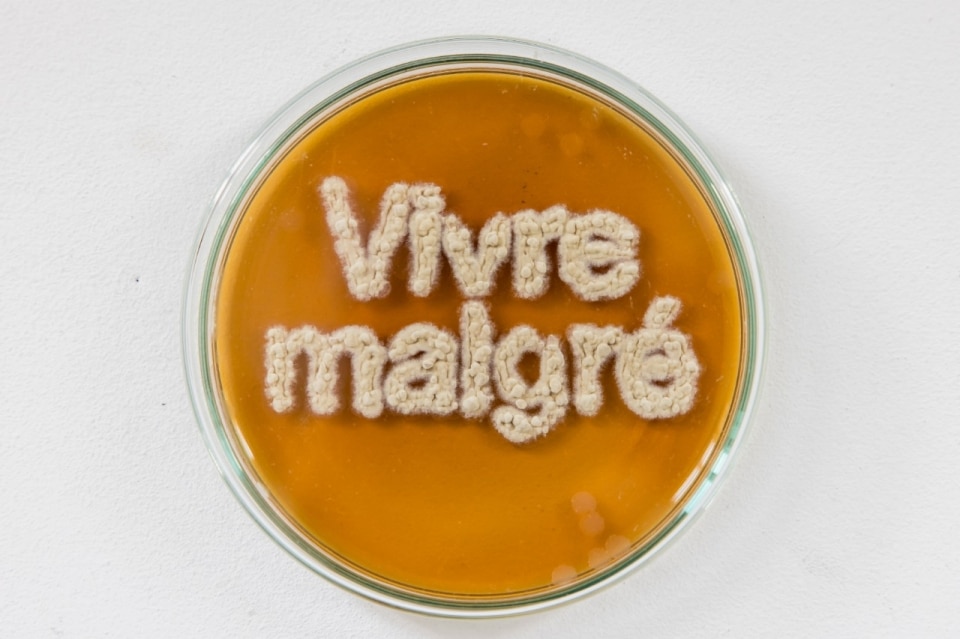

In France, design is often seen as the child of a lesser god. The prejudice still holds in a country where generations of designers were trained in “decoration” at fine arts academies, with art – the cumbersome firstborn – considered a loftier repository of cultural and conceptual value. And yet, there is no other European capital where the two disciplines seem to flow into each other like communicating vessels as they do in Paris. Especially during Paris Design Week, from September 4 to 13, 2025, the fluid boundary between art and design has taken on the form of an unclassifiable contamination. This is due to the chosen format – exhibitions – its deliberately elusive typologies, and the destination of the objects, clearly intended for collectors.

Within a packed program, it was the small exhibitions that highlighted the most interesting projects of the Paris design week. This is thanks above all to a tighter, more focused selection: at NéoPaléo, held at the Galerie des Ateliers de Paris under the aegis of the Bureau du Design, de la Mode et des Métiers d’Art de la Ville de Paris and curated by the duo BehaghelFoiny, fifteen designers proposed a “time capsule of design” that revisits primordial gestures and materials through contemporary manufacturing processes. It’s within this apparent contradiction that the most compelling works emerge.
The Strat Chair and Strat Bench by Nicolas Zanoni are made of layers of XPS, a construction material thermally shaped with an intentionally rough, instinctive gesture. For his table The Last Dragonfly, Dorian Renard subverts the technique of blown glass by using PETG, a plastic material also employed for his sea-anemone-inspired vases. Alec Vivier-Reynaud reclaims a natural element that has accompanied us since time immemorial, mycelium, to grow and transform it into an expressive medium, as shown by his work Vivre malgré.

At Lafayette Anticipations, a festive spirit permeated the rooms of the foundation redesigned by OMA. Once again it was an exhibition – Design Disco Club – that allowed design to unleash some of its best energies, taking the pulse – as curator Christopher Dessus hopes – of the temperature of contemporary creation. The scenography by Paf Atelier draws inspiration from the 1976 hit Disco Inferno, while the selected projects channel tensions that veer toward liberating impulses (the table I will love you forever if you bring desert in my living room by Soft Baroque; the drinking station Negroni Station by Studio Douze Degré), enigmatic and totemic presences (Quentin Vuong’s armchair Fauteuil n°1 from the After the rain collection; Julien Carretero’s lamp Balises), or joyful, informal comfort (Eclipse Daybed by Petite Friture).
In France, design is often seen as the child of a lesser god. (...) And yet, there is no other European capital where the art and design seem to flow into each other like communicating vessels as they do in Paris.
Scattered throughout, each privileging its own perspective, pretext, or stubbornly contrarian research, other exhibitions made the design week experience composite and engaging. They revealed, for instance, how even a pairing of colors can fully evoke ambiguous works, materials, and objects: such is the case with Vert nuit, noir jade, a group show built chromatically on the ironic and unexpected dialogue between green and black. A domestic setting is reimagined by the installation Interieurs. An apartment to Inhabit, an art experience to live, staged at Gran Tour on rue de Turenne by ColAAb Art + Function, where Morgane Tschiember’s Skin Poems and volume-seats trapped in bondage stand out. Not far away, on the other side of the Marais, typological research takes center stage at gallery A1043, where Inès Bressand reinvents dry-grass baskets in forms yet unnamed, balancing between soft sculptural tension and a sense of domestic presence.
As has been the custom for the past three years, the Institut du Monde Arabe presented the work of the finalists of its Prix du Design, chaired this year by Lina Ghotmeh. Winner of the Grand Prix is Ala Tannir, with a video project documenting the renovation of her childhood home on the Beirut seafront. Among the Talents Émergents, notable mentions include Dunes, an intriguing luminous object by Algerian designer Djaffar Zizi, and Comme un Phare, lamps inspired by Tunisian lighthouses by Fares Dhifi.
Just outside the official program of design week, two other exhibitions seem to echo –consciously or not – the same tension between design practice and artistic research. Almost coincidentally, the Marais space of Galleria Continua presents Pièces à vivre, a mirrored reflection of contemporary art’s ability to question conventions and unveil the symbolic dynamics of living. Bringing us back, with irony, to the ground of functionality is the small exhibition staged by Yvon Lambert to present the series Coppie di fatto e altro. La funzione dipende dalla forma by Nathalie du Pasquier, a regular at Lambert. Her collection of vases is not only a wink at the complementarity of couple life but also a reminder – rarely invoked during these design days – of the possibility for objects to exist not just as inspiring, contemplative presences but also as companions to daily life, with all its activities and poetry.
Opening image: View of the exhibition Pièces à vivre, 2025. © Paul Hennebelle. Paris Adagp 2025. Courtesy the artists and Galleria Continua















